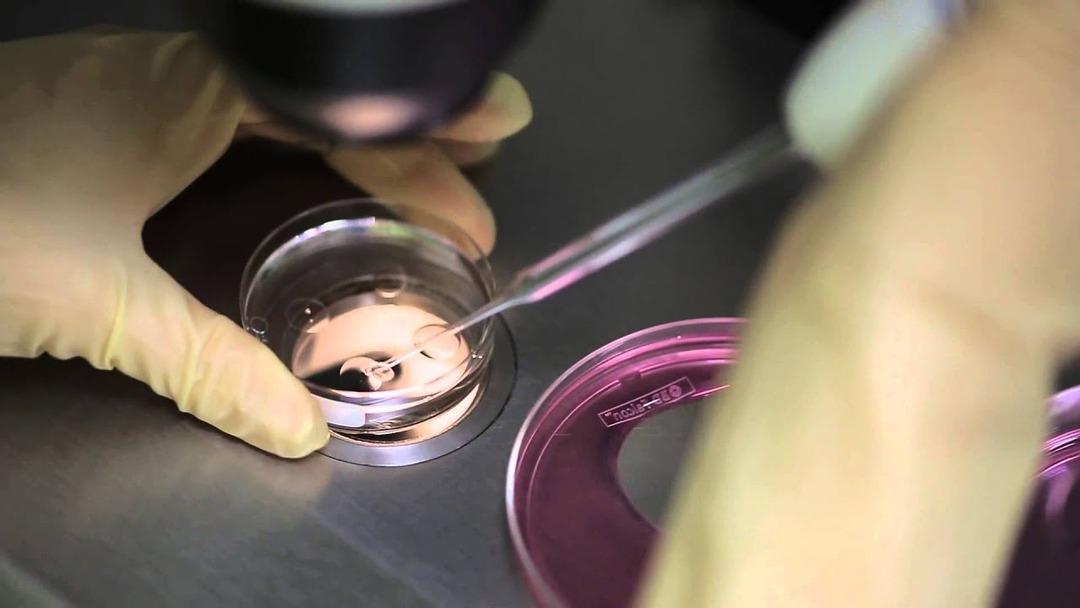
Skandal olay! Bir kadın yanlışlıkla başka birinin bebeğini doğurdu! Aylar sonra öğrendiler... 1

Avustralya’da bir tüp bebek merkezinde skandal bir olay yaşandı. Merkezde yaşanan karışıklık nedeniyle bir kadın, bilmeden bir başka kadının bebeğini dünyaya getirdi.
The Guardian gazetesinin aktardığına göre, olay Queensland’deki bir tüp bebek merkezinde yaşandı. kliniklerinden birinde bir kadına “yanlışlıkla” başka bir embriyo transfer edilmesinin, diğer bir deyişle kadının bir başka kadının çocuğunu doğurmasının ardından yaşanan olaydan üzgün olduklarını açıkladı.

Kimliği açıklanmayan kadın, geçen yıl doğum yaptı. Anne-babanın geri kalan embriyoların bir başka tük bebek sağlayıcısına transfer edilmesini talep etmesinin ardından olay ortaya çıktı. Kurumdan yapılan açıklamada, bu talebin ardından ebeveynlere ait beklenen sayıda embriyo bulunmadığı, çifte ait fazladan bir embriyonun kaldığının görüldüğü belirtildi.
Yöneti Michael Knaap, yaşanan karışıklık için özür diledi. Knaap, açıklamasında, “Monash IVF’de hepimiz yıkıldık. İlgili herkesten özür diliyoruz” diyerek ek denetimlerin yapıldığını ve bunun “münferit bir olay olduğundan emin olduklarını” savundu.

Skandalın yaşandığı tüp bebek merkezinde ağustos ayında da hatalı bir genetik inceleme sırasında embriyoları yok ettiği iddialarının ardından 700’ü aşkın eski hastası ile 56 milyon dolarlık bir tazminat anlaşmasına varmıştı.